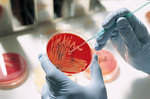

Adelaide wins $48 million for new research
 Research Research
The University of Adelaide has been awarded more than $48 million in new funding from the Australian Research Council (ARC) and the National Health and Medical Research Council (NHMRC) for projects that aim to impact on people's lives in Australia and around the globe.
Here are the results of those funding announcements.
| ARC funding |
|
 |
The Australian Research Council (ARC) has awarded more than $12.7 million to the University of Adelaide for new research projects starting in 2007.
Adelaide was again the top-funded university in South Australia, and was awarded:
- 31 Discovery Projects worth more
than $9.5 million;
- 11 Linkage Projects with industry
worth more than $2 million;
- 3 Linkage Infrastructure, Equipment
and Facilities grants worth $951,000;
- 1 Linkage International Fellowship
of $40,306; and
- 1 Discovery Indigenous Researcher Development grant of $85,800.
Adelaide's Discovery grants include major, groundbreaking projects that have the potential to improve people's lives in
Australia and across the world, such as:
- $541,063 to investigate methods of reducing soot in industrial flames, benefiting the community by reducing air pollution and improving health and safety (Associate Professor Gus Nathan, Dr Bassam Dally and others - School of Mechanical Engineering);
- $201,000 for the improvement of intelligent surveillance systems, enabling the tracking of suspicious individuals and vehicles in busy environments and helping to safeguard Australia from terrorism and crime (Professor Mike Brooks and Dr Anthony Dick - School of Computer Science); and
- $873,000 to better understand calcium storage and water flow in plants, to benefit agricultural production and quality of life (Professor Roger Leigh, Professor Steve Tyerman, Dr Brent Kaiser - School of Agriculture, Food & Wine).
In addition to the ARC funding, more than $3 million has been pledged in cash and in-kind support from industry partners for the University of Adelaide's Linkage Projects.
Seven fellowships were awarded to University of Adelaide researchers. The most prestigious of these are the Australian Professorial Fellows. Adelaide's Professor Steve Tyerman (School of Agriculture, Food & Wine) and Professor Mathai Varghese (School of Mathematical Sciences) have been named among the ARC Australian Professorial Fellows, with funding commencing in 2007.
The Linkage International Fellowship has been awarded to ARC Postdoctoral Fellow Dr Ben Kear (School of Earth & Environmental Sciences). Dr Kear aims to learn more about climate change through the study of Australian Cretaceous fauna. This work is being conducted in collaboration with the Natural History Museum in London.
Adelaide's three Federation Fellows - Professor Alan Cooper (School of Earth & Environmental Sciences), Professor Graeme Hugo (School of Social Sciences) and Professor Mark Tester (Australian Centre for Plant Functional Genomics) - have all been successful in winning ARC funding for research in their various fields, bringing in more than $1.15 million between them.
The University's Discovery Indigenous Researchers Development grant went to PhD student Richard Bosworth (School of Agriculture, Food & Wine). The $85,800 funding over three years is aimed at better understanding the competition between native and introduced herbivores on Kangaroo Island, which could lead to better management of land resources.
"This is an excellent result for the University of Adelaide, with an extremely high calibre of research projects being funded by the ARC," said Deputy Vice-Chancellor (Research) Professor Alan Johnson.
"The new funding... will drive research here in Adelaide that has the potential to make a huge impact on the environment, our understanding of human thought and behaviour, the food we eat, the way we cope with future pandemics, how we defend our nation and its citizens, and many, many other fields in Australia and right around the world.
"I am especially pleased with the strong support we have had for research projects in partnership with industry. Industry links continue to be important to the University of Adelaide, and these partnerships result in real benefits for the State and the nation," he said.
Story by David Ellis
| NHMRC funding |
|
 |
The University of Adelaide has confirmed its reputation as the leading medical research institution in South Australia after winning $35.3 million in funding from the National Health and Medical Research Council (NHMRC).
This represents the lion's share of the $46 million awarded to South Australian universities.
Major beneficiaries in the Faculty of Health Sciences include a $10.3 million program grant for reproductive health research, a $2 million Clinical Centre of Research Excellence grant for nutritional physiology and a $1 million project grant for prenatal corticosteroids research.
This year's funding is an increase of $11.1 million on the 2005 NHMRC grants awarded to the University.
"This is an outstanding result for the University," Deputy Vice-Chancellor (Research) Professor Alan Johnson said. "I am pleased that the NHMRC has recognised our research strength in areas such as reproductive medicine, orthopaedics, children's health, infectious diseases and biomedical science.
"The $35 million awarded to the University is further proof that we are one of the top universities in Australia for research and our work continues to make a significant impact on society," Professor Johnson said.
Funding highlights include:
- Professor Rob Norman, the Director of the Research Centre for Reproductive Health, has been awarded $10.3 million for a program to investigate periconceptual foundations for a healthy start to life;
- Professor Michael Horowitz from the Discipline of Medicine has received $2 million for research into nutritional physiology, interventions and outcomes;
- Professor Caroline Crowther from the Discipline of Obstetrics & Gynaecology has been awarded $1 million for a randomised controlled trial of early school-age outcomes after exposure to repeat prenatal corticosteroids.
In all, the University received 46 new Project grants, a Clinical Centre for Research Excellence grant, five fellowships, as well as the substantial Program grant.
University researchers to benefit come from the Faculty of Health Sciences, Faculty of Sciences, the Women's and Children's Hospital, Royal Adelaide Hospital, Queen Elizabeth Hospital, Institute of Medical and Veterinary Science, the Child Health Research Institute and the Hanson Institute.
Nationally, the Federal Government provided $529 million in health and medical research for new projects beginning in 2007.
Story by Candy Gibson
|